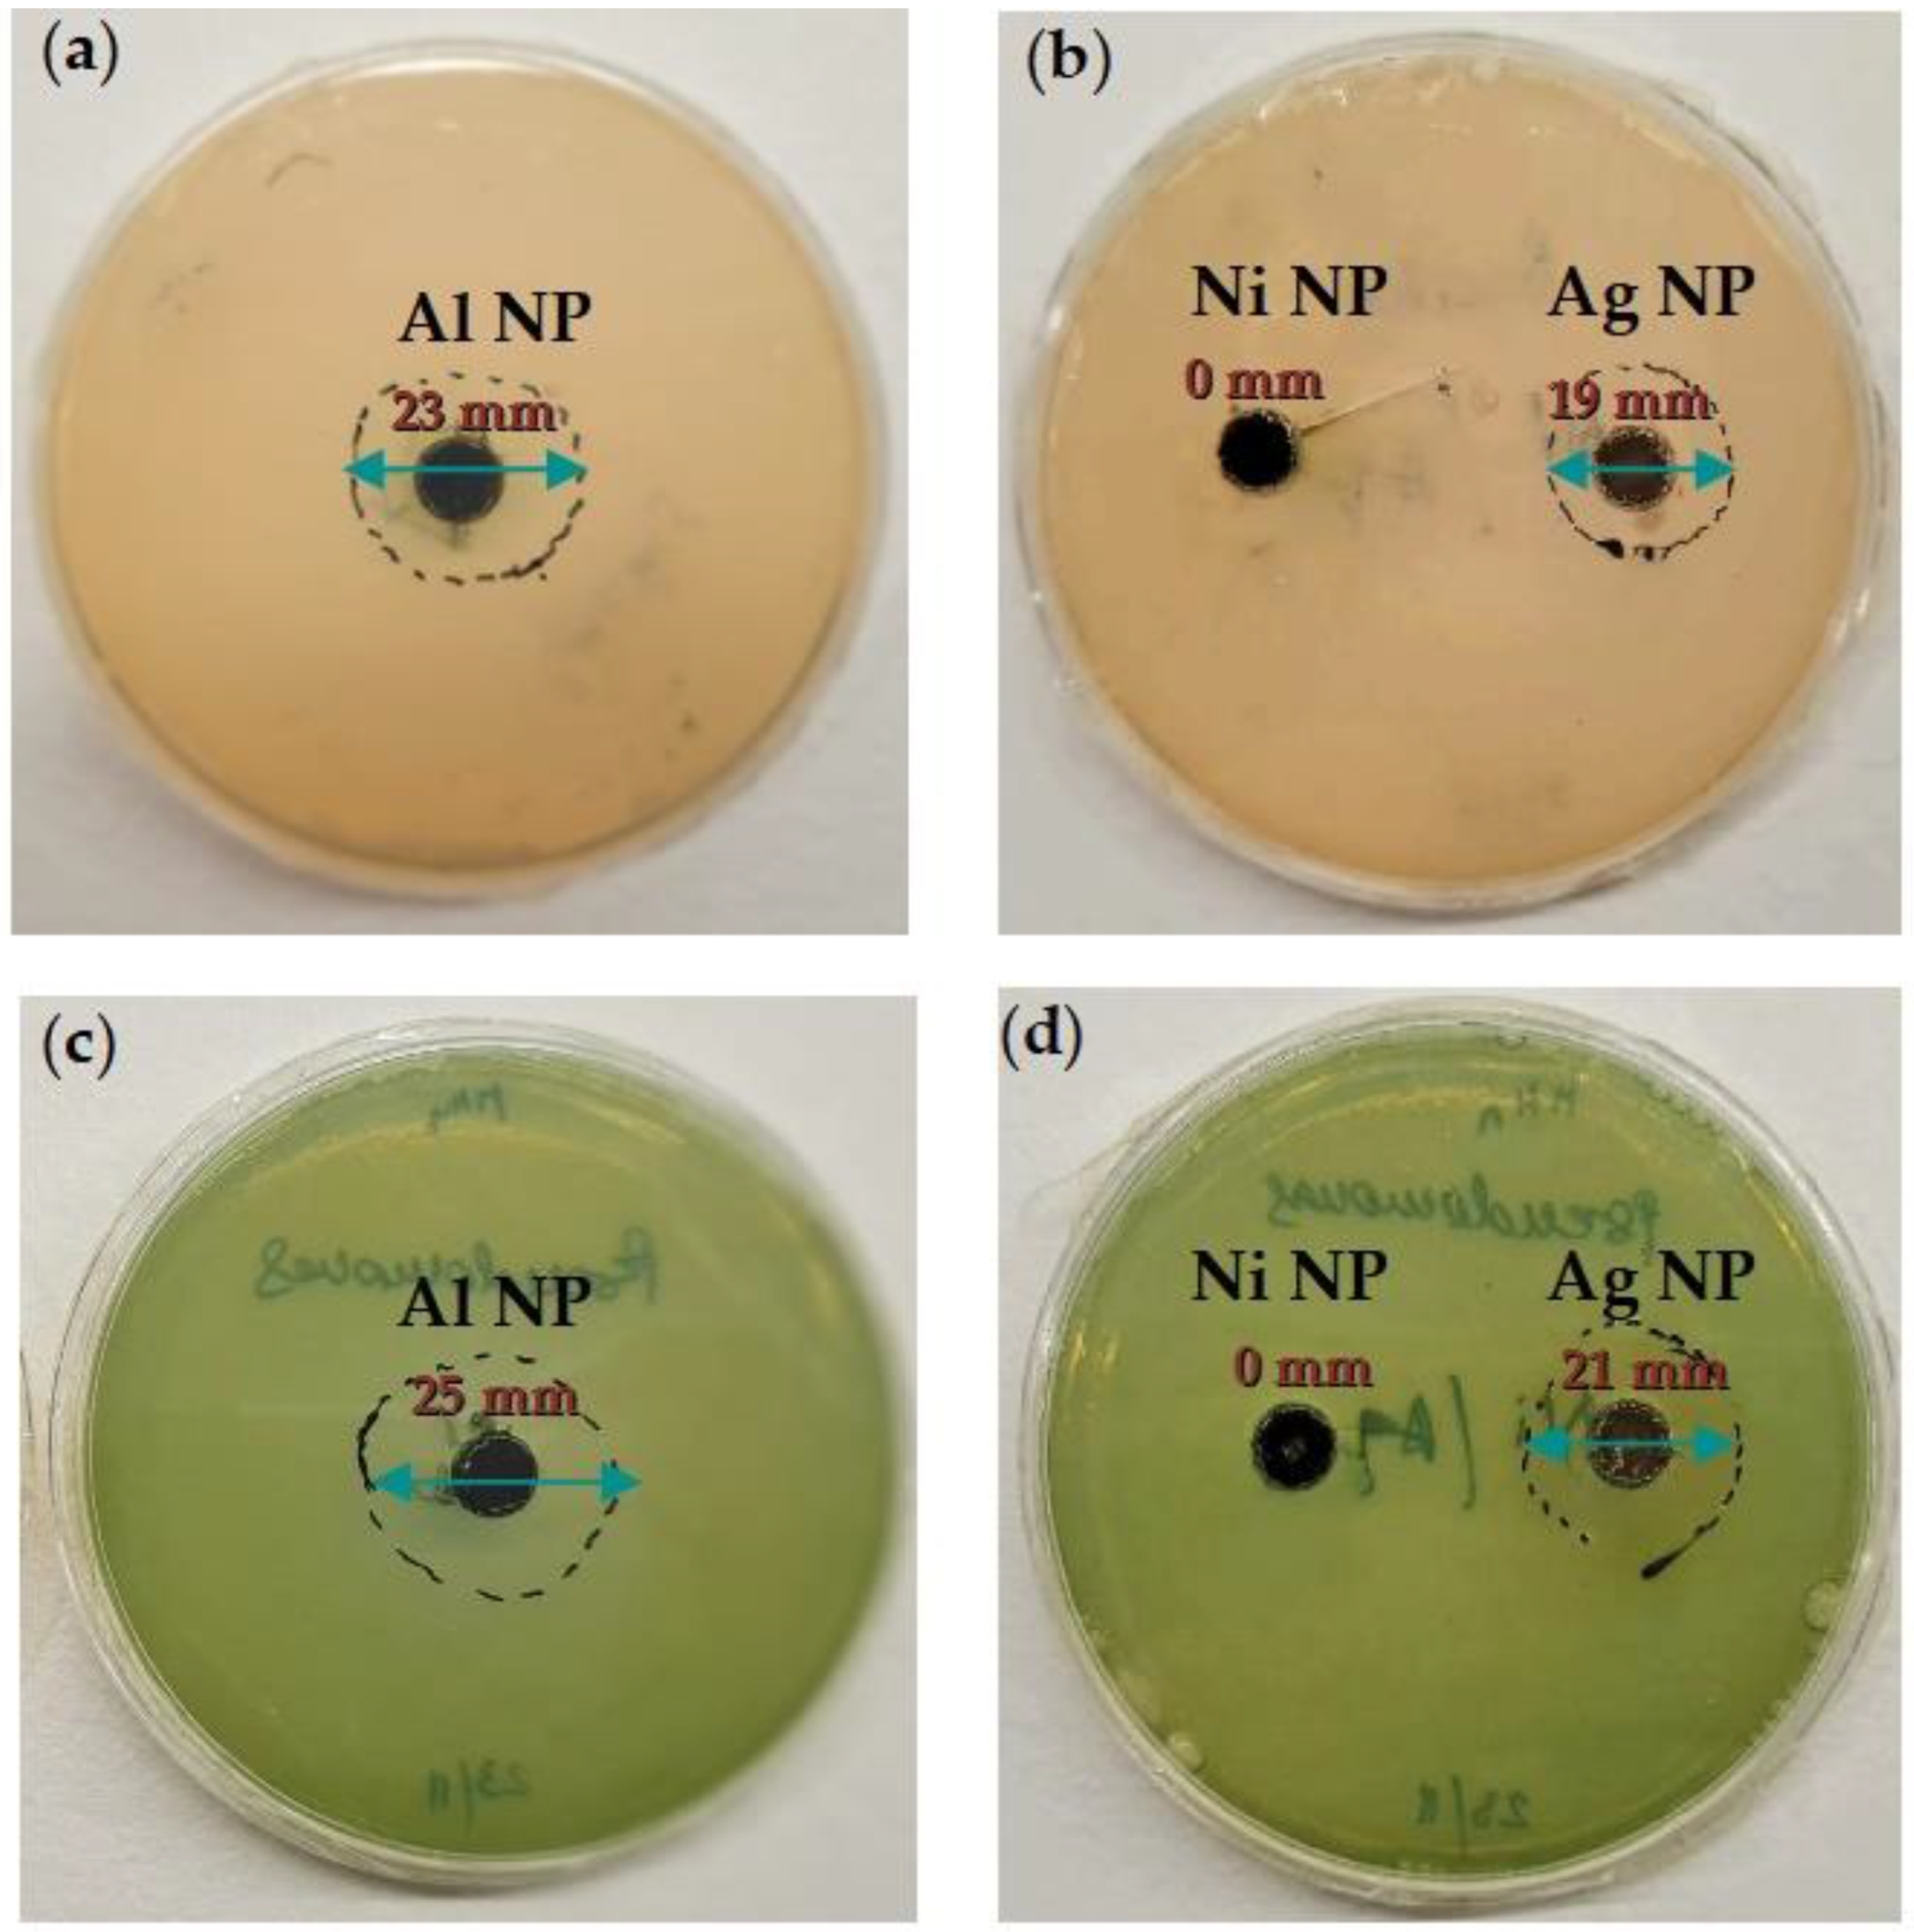
Coatings 13 01201 g006

Epoxy Coating Modification with Metal Nanoparticles to Improve the Anticorrosion, Migration, and Antibacterial Properties
Abstract
1. Introduction
2. Materials and Methods
2.1. Materials
2.2. Preparation of the Epoxy Coating/Nanocomposite
2.3. Characterization of the Epoxy Coating/Nanocomposite
3. Results and Discussion
3.1. SEM and EDS Analysis of Epoxy Coating/Nanocomposite
3.2. EIS Analysis of Epoxy Coating/Nanocomposite
3.3. Antibacterial Activity of the Al, Ni, and Ag Nanoparticles
3.4. Migration Ability and Antibacterial Activity of the Nanocomposites
4. Conclusions
Author Contributions
Funding
Institutional Review Board Statement
Informed Consent Statement
Data Availability Statement
Acknowledgments
Conflicts of Interest
References
- Khan, I.; Saeed, K.; Khan, I. Nanoparticles: Properties, applications, and toxicities. Arab. J. Chem. 2019, 12, 908–931. [Google Scholar] [CrossRef]
- Jamkhande, P.G.; Ghule, N.W.; Bamer, A.H.; Kalaskar, M.G. Metal nanoparticles synthesis: An overview on methods of preparation, advantages and disadvantages, and applications. J. Drug Deliv. Sci. Technol. 2019, 53, 101174. [Google Scholar] [CrossRef]
- Nguyen-tri, P.; Nguyen, T.A.; Carriere, P.; Xuan, C.N. Nanocomposite Coatings: Preparation, Characterization, Properties, and Applications. Int. J. Corros. 2018, 2018, 19. [Google Scholar] [CrossRef]
- Tanveer, M.; Farooq, A.; Ata, S.; Bibi, I.; Sultan, M.; Iqbal, M.; Jabeen, S.; Gull, N.; Islam, A.; Khan, R.U.; et al. Aluminum nanoparticles, chitosan, acrylic acid and vinyltrimethoxysilane based hybrid hydrogel as a remarkable water super-absorbent and antimicrobial activity. Surf. Interfaces 2021, 25, 101285. [Google Scholar] [CrossRef]
- Zhang, G.; Li, B.; Liu, J.; Luan, M.; Yue, L.; Jiang, X.T.; Yu, K.; Guan, Y. The bacterial community significantly promotes cast iron corrosion in reclaimed wastewater distribution systems. Microbiome 2018, 6, 222. [Google Scholar] [CrossRef]
- Wang, J.; Liu, G.; Wang, J.; Xu, X.; Shao, Y.; Zhang, Q.; Liu, Y.; Qi, L.; Wang, H. Current status, existent problems, and coping strategy of urban drainage pipeline network in China. Environ. Sci. Pollut. Res. 2021, 28, 43035–43049. [Google Scholar] [CrossRef]
- Sun, H.; Shi, B.; Lytle, D.A.; Bai, Y.; Wang, D. Formation, and release behavior of iron corrosion products under the influence of bacterial communities in a simulated water distribution system. Environ. Sci. Process. Impacts 2014, 16, 576–585. [Google Scholar] [CrossRef]
- Lou, Y.; Chan, W.; Cui, T.; Qian, H.; Huang, L.; Ma, L.; Hao, X.; Zhang, D. Microbiologically influenced corrosion inhibition of carbon steel via biomineralization induced by Shewanella putrefaciens. Mater. Degrad. 2021, 5, 59. [Google Scholar] [CrossRef]
- Brindha, T.; Rathinam, R.; Dheenadhayalan, S.; Sivakumar, R. Nanocomposite Coatings in Corrosion Protection Applications: An Overview. Orient. J. Chem. 2021, 37, 1062–1067. [Google Scholar]
- Kausar, A. A review of high performance polymer nanocomposites for packaging applications in electronics and food industries. J. Plast. Film Sheeting 2020, 36, 94–112. [Google Scholar] [CrossRef]
- Zheng, K.; Setyawati, M.I.; Leong, D.T.; Xie, J. Antimicrobial silver nanomaterials. Coord. Chem. Rev. 2018, 357, 1–17. [Google Scholar] [CrossRef]
- Rai, M.; Shegokar, R. Metal Nanoparticles in Pharma. In Metal Nanoparticles in Pharma; Springer International Publishing: Cham, Switzerland, 2017; pp. 1–493. [Google Scholar]
- Franco, D.; Calabrese, G.; Guglielmino, S.P.P.; Conoci, S. Metal-Based Nanoparticles: Antibacterial Mechanisms and Biomedical Application. Microorganisms 2022, 10, 1778. [Google Scholar] [CrossRef]
- Giraldo Mejía, H.F.; Yohai, L.; Pedetta, A.; Herrera Seitz, K.; Procaccini, R.A.; Pellice, S.A. Epoxy-silica/clay nanocomposite for silver-based antibacterial thin coatings: Synthesis and structural characterization. J. Colloid Interface Sci. 2017, 508, 332–341. [Google Scholar] [CrossRef]
- Hussain, Z.; Tahir, S.A.; Mahmood, K.; Ali, A.; Arshad, M.I.; Ikram, S.; Nabi, M.A.U.; Ashfaq, A.; Rehman, U.U.; Muddassir, Y. Synthesis and characterization of silver nanoparticles with epoxy resin. Dig. J. Nanomater. Biostructures 2020, 15, 873–883. [Google Scholar] [CrossRef]
- Manjumeena, R.; Venkatesan, R.; Duraibabu, D.; Sudha, J.; Rajendran, N.; Kalaichelvan, P.T. Green Nanosilver as Reinforcing Eco-Friendly Additive to Epoxy Coating for Augmented Anticorrosive and Antimicrobial Behavior. Silicon 2015, 8, 277–298. [Google Scholar] [CrossRef]
- Chaudhari, B.; Panda, B.; Šavija, B.; Paul, S.C. Microbiologically Induced Concrete Corrosion: A Concise Review of Assessment Methods, Effects, and Corrosion-Resistant Coating Materials. Materials 2022, 15, 4279. [Google Scholar] [CrossRef]
- Shen, W.; Zhang, T.; Ge, Y.; Feng, L.; Feng, H.; Li, P. Multifunctional AgO/epoxy nanocomposites with enhanced mechanical, anticorrosion and bactericidal properties. Prog. Org. Coat. 2021, 152, 106130. [Google Scholar] [CrossRef]
- Shetty, P.; Bhushan, S.; Vidya, A.; Kodialbail, S. Biocorrosion Behavior of Epoxy—Based Multilayer Nanocomposite Coatings. J. Bio- Tribo-Corrosion 2023, 9, 45. [Google Scholar] [CrossRef]
- Leygraf, C.; Wallinder, I.O.; Tidblad, J.; Graedel, T. Appendix I: The Atmospheric Corrosion Chemistry of Silver. In Atmospheric Corrosion, 2nd ed.; John Wiley & Sons, Inc.: Hoboken, NJ, USA, 2016; pp. 337–347. [Google Scholar]
- Majeed, H.M.; Wadee, S.A. Antibacterial Activity and Mechanism of Nickel Nanoparticles against Multidrug Resistant Pseudomonas aeruginosa. Ann. Trop. Med. Public Health 2019, 22, 157–168. [Google Scholar] [CrossRef]
- EN 877; Cast Iron Pipes and Fittings, Their Joints and Accessories for the Evacuation of Water from Buildings—Requirements, Test Methods and Quality Assurance. European Committee for Standardization: Brussels, Belgium, 2006.
- ISO/TS 16782; Clinical Laboratory Testing—Criteria for Acceptable Lots of Dehydrated Mueller-Hinton Agar and Broth for Antimicrobial Susceptibility Testing. International Organization for Standardization: Geneva, Switzerland, 2016.
- ISO 22196; Plastics—Measurement of Antibacterial Activity on Plastics Surfaces. International Organization for Standardization: Geneva, Switzerland, 2007.
- ISO 4833–1; Microbiology of the Food Chain—Horizontal Method for the Enumeration of Microorganisms—Part 1: Colony Count at 30 °C by the Pour Plate Technique. International Organization for Standardization: Geneva, Switzerland, 2018.
- Ghanbari, A.; Attar, M.M. A study on the anticorrosion performance of epoxy nanocomposite coatings containing epoxy-silane treated nano-silica on mild steel substrate. J. Ind. Eng. Chem. 2015, 23, 145–153. [Google Scholar] [CrossRef]
- Obot, I.B.; Madhankumar, A. Synergistic effect of iodide ion addition on the inhibition of mild steel corrosion in 1 M HCl by 3-amino-2-methylbenzylalcohol. Mater. Chem. Phys. 2016, 177, 266–275. [Google Scholar] [CrossRef]
- Samardžija, M.; Alar, V.; Špada, V.; Stojanović, I. Corrosion Behaviour of an Epoxy Resin Reinforced with Aluminium Nanoparticles. Coatings 2022, 12, 1500. [Google Scholar] [CrossRef]
- Solomon, M.M.; Gerengi, H.; Kaya, T.; Umoren, S.A. Performance Evaluation of a Chitosan/Silver Nanoparticles Composite on St37 Steel Corrosion in a 15% HCl Solution. ACS Sustain. Chem. Eng. 2017, 5, 809–820. [Google Scholar] [CrossRef]
- Anjum, M.J.; Ali, H.; Khan, W.Q.; Zhao, J.; Yasin, G. Chapter 11—Metal/Metal Oxide Nanoparticles as Corrosion Inhibitors, 1st ed.; Elsevier: Amsterdam, The Netherlands, 2020; pp. 181–201. [Google Scholar]
- Jain, P.; Patidar, B.; Bhawsar, J. Potential ofNanoparticles asa Corrosion Inhibitor: A Review. J. Bio-Tribo-Corros. 2020, 6, 43. [Google Scholar] [CrossRef]
- Geoprincy, G.; Nagendhra Gandhi, N.; Renganathan, S. Novel antibacterial effects of alumina nanoparticles on Bacillus cereus and Bacillus subtilis in comparison with antibiotics. Int. J. Pharm. Pharm. Sci. 2012, 4, 544–548. [Google Scholar]
- Niroumandrad, S.; Rostami, M.; Ramezanzadeh, B. Effects of combined surface treatments of aluminium nanoparticle on its corrosion resistance before and after inclusion into an epoxy coating. Prog. Org. Coat. 2016, 101, 486–501. [Google Scholar] [CrossRef]
- Samardžija, M.; Kurtela, M.; Vuković Domanovac, M.; Alar, V. Anticorrosion and Antibacterial Properties of Al NP—Epoxy Nanocomposite Coating on Grey Cast Iron. Coatings 2023, 13, 898. [Google Scholar] [CrossRef]
- Feichtenschlager, B.; Pabisch, S.; Svehla, J.; Peterlik, H.; Sajjad, M.; Koch, T.; Kickelbick, G. Epoxy Resin Nanocomposites: The Influence of Interface Modification on the Dispersion Structure—A Small-Angle-X-ray-Scattering Study. Surfaces. Surfaces 2020, 3, 664–682. [Google Scholar] [CrossRef]
- Pavapootanont, G.; Wongpanya, P.; Viyanit, E.; Lothongkum, G. Corrosion behavior of Ni steels in aerated 3.5-wt.% NaCl solution at 25 °C by potentiodynamic method. Eng. J. 2018, 22, 1–12. [Google Scholar] [CrossRef]
- Keast, V.J. Atmospheric Corrosion of Silver and Silver Nanoparticles. Corros. Mater. Degrad. 2022, 3, 221–234. [Google Scholar] [CrossRef]
- Bordbar, S.; Rezaeizadeh, M.; Kavian, A. Improving thermal conductivity and corrosion resistance of polyurea coating on internal tubes of gas heater by nano silver. Prog. Org. Coat. 2020, 146, 105722. [Google Scholar] [CrossRef]
- Asghari, E.; Kaltschmidt, B.P.; van Merwyk, L.; Huser, T.; Kaltschmidt, C.; Hutten, A. Pseudomonasaeruginosa Clusters Toxic Nickel Nanoparticles to Enhance Survival. Microorganisms 2022, 10, 2220. [Google Scholar] [CrossRef] [PubMed]
- Hussain, A.; Ahmad, M.N.; Jalal, F.; Yameen, M.; Falak, S.; Noreen, S.; Naz, S.; Nazir, A.; Iftikhar, S.; Soomro, G.A.; et al. Investigating the antibacterial activity of POMA nanocomposites. Polish J. Environ. Stud. 2019, 28, 4191–4198. [Google Scholar] [CrossRef]
- Fonseca, S.; Cayer, M.; Ahmmed, K.M.T.; Khadem-mohtaram, N.; Charette, S.J.; Brouard, D. Characterization of the Antibacterial Activity of an SiO2 Nanoparticular Coating to Prevent Bacterial Contamination in Blood Products. Antibiotics 2022, 11, 107. [Google Scholar] [CrossRef]
- Mukherjee, A.; Mohammed Sadiq, I.; Prathna, T.C.; Chandrasekaran, N. Antimicrobial activity of aluminium oxide nanoparticles for potential clinical applications. Sci. Microb. Pathog. Commun. Curr. Res. Technol. Adv. 2011, 4, 245–251. [Google Scholar]
- Li, Z.; Ma, J.; Ruan, J.; Zhuang, X. Using Positively Charged Magnetic Nanoparticles to Capture Bacteria at Ultralow Concentration. Nanoscale Res. Lett. 2019, 14, 195. [Google Scholar] [CrossRef]
- Jiang, W.; Mashayekhi, H.; Xing, B. Bacterial toxicity comparison between nano- and micro-scaled oxide particles. Environ. Pollut. 2009, 157, 1619–1625. [Google Scholar] [CrossRef] [PubMed]
- Yasakau, K.A.; Zheludkevich, M.L.; Lamaka, S.V.; Ferreira, M.G.S. Mechanism of corrosion inhibition of AA2024 by rare-earth compounds. J. Phys. Chem. B 2006, 110, 5515–5528. [Google Scholar] [CrossRef] [PubMed]
- Sharmin, S.; Rahaman, M.M.; Sarkar, C.; Atolani, O.; Islam, M.T.; Adeyemi, O.S. Nanoparticles as antimicrobial and antiviral agents: A literature-based perspective study. Heliyon 2021, 7, 5515–5528. [Google Scholar] [CrossRef]
- Gudkov, S.V.; Burmistrov, D.E.; Smirnova, V.V.; Semenova, A.A.; Lisitsyn, A.B. A Mini Review of Antibacterial Properties of Al2O3 Nanoparticles. Nanomaterials 2022, 12, 2635. [Google Scholar] [CrossRef] [PubMed]

| Al NP | Ni NP | Ag NP | ||||||
|---|---|---|---|---|---|---|---|---|
| Elements | wt.% | +/− | Elements | wt.% | +/− | Elements | wt.% | +/− |
| Al | 98.85 | 0.24 | Ni | 99.21 | 0.25 | Ag | 98.94 | 0.32 |
| Cr | 0.08 | 0.01 | Cu | 0.28 | 0.05 | Cr | 0.41 | 0.10 |
| Fe | 0.03 | 0.43 | Si | 0.26 | 0.05 | Co | 0.33 | 0.04 |
| Residue | 1.04 | 0.01 | Co | 0.11 | 0.02 | Si | 0.33 | 0.02 |
| Total | 100 | - | Residue | 0.14 | 0.01 | Total | 100 | - |
| Total | 100 | |||||||
| Sample | Epoxy Coating (g) | Hardener (g) | m (Al NP) (g) | m (Ni NP) (g) | m (Ag NP) (g) | Thickness (μm) |
|---|---|---|---|---|---|---|
| Epoxy Coating | 30 | 7.5 | - | - | - | 249.1 |
| 1% Al NP Nanocomposite | 30 | 7.5 | 0.4545 | - | - | 256.1 |
| 1% Ni NP Nanocomposite | 30 | 7.5 | - | 0.4545 | - | 266.5 |
| 1% Ag NP Nanocomposite | 30 | 7.5 | - | - | 0.4545 | 264.9 |
| Samples | Re, Ω | Rcoat, Ω | CPEcoat, Ssecn | n | Rct,Ω | CPEdl, Ssecn | n | CPE, % |
|---|---|---|---|---|---|---|---|---|
| After 24 h | ||||||||
| Epoxy Coating | 195.9 | 2.55 × 108 | 4.8 × 10−10 | 0.9641 | 1.76 × 108 | 2.32 × 10−9 | 0.9305 | - |
| 1% Al NP Nanocomposite | 116.8 | 5.68 × 108 | 6.97 × 10−11 | 0.9379 | 2.034 × 108 | 5.67 × 10−10 | 0.9505 | 54.87 |
| 1% Ni NP Nanocomposite | 204.1 | 7.90 × 108 | 2.72 × 10−12 | 1 | 4.42 × 108 | 1.69 × 10−9 | 1 | 67.72 |
| 1% AgNP Nanocomposite | 217.1 | 8.89 × 108 | 5.95 × 10−12 | 1 | 8.81 × 108 | 2.12 × 10−10 | 1 | 71.32 |
| After 10 days | ||||||||
| Epoxy Coating | 153.9 | 5.87 × 106 | 7.35 × 10−10 | 0.924 | 4.87 × 104 | 4.19 × 10−9 | 0.9951 | - |
| 1% Al NP Nanocomposite | 100.0 | 1.67 × 107 | 5.63 × 10−10 | 0.9102 | 2.35 × 106 | 3.85 × 10−10 | 0.9862 | 64.85 |
| 1% Ni NP Nanocomposite | 165.3 | 2.34 × 107 | 1.32 × 10−11 | 0.9589 | 3.34 × 106 | 7.53 × 10−10 | 0.9357 | 74.91 |
| 1% AgNP Nanocomposite | 135.5 | 2.57 × 107 | 3.64 × 10−11 | 0.9525 | 4.73 × 106 | 9.23 × 10−10 | 0.9768 | 77.16 |
| Nanocomposite | ||||
|---|---|---|---|---|
| Epoxy Coating | 1% Al NP | 1% Ag NP | 1% Ni NP | |
| P. aerugionosa | 4.17 ± 0.09 | 61.46 ± 2.64 | 45.83 ± 4.05 | 11.46 ± 0.92 |
| B. subtilis | 3.44 ± 0.11 | 55.31 ± 0.16 | 42.19 ± 1.41 | 11.25 ± 0.15 |
Disclaimer/Publisher’s Note: The statements, opinions and data contained in all publications are solely those of the individual author(s) and contributor(s) and not of MDPI and/or the editor(s). MDPI and/or the editor(s) disclaim responsibility for any injury to people or property resulting from any ideas, methods, instructions or products referred to in the content. |
© 2023 by the authors. Licensee MDPI, Basel, Switzerland. This article is an open access article distributed under the terms and conditions of the Creative Commons Attribution (CC BY) license (https://creativecommons.org/licenses/by/4.0/).
Share and Cite
Samardžija, M.; Stojanović, I.; Vuković Domanovac, M.; Alar, V. Epoxy Coating Modification with Metal Nanoparticles to Improve the Anticorrosion, Migration, and Antibacterial Properties. Coatings 2023, 13, 1201. https://doi.org/10.3390/coatings13071201
Samardžija M, Stojanović I, Vuković Domanovac M, Alar V. Epoxy Coating Modification with Metal Nanoparticles to Improve the Anticorrosion, Migration, and Antibacterial Properties. Coatings. 2023; 13(7):1201. https://doi.org/10.3390/coatings13071201
Chicago/Turabian StyleSamardžija, Marina, Ivan Stojanović, Marija Vuković Domanovac, and Vesna Alar. 2023. "Epoxy Coating Modification with Metal Nanoparticles to Improve the Anticorrosion, Migration, and Antibacterial Properties" Coatings 13, no. 7: 1201. https://doi.org/10.3390/coatings13071201
APA StyleSamardžija, M., Stojanović, I., Vuković Domanovac, M., & Alar, V. (2023). Epoxy Coating Modification with Metal Nanoparticles to Improve the Anticorrosion, Migration, and Antibacterial Properties. Coatings, 13(7), 1201. https://doi.org/10.3390/coatings13071201

